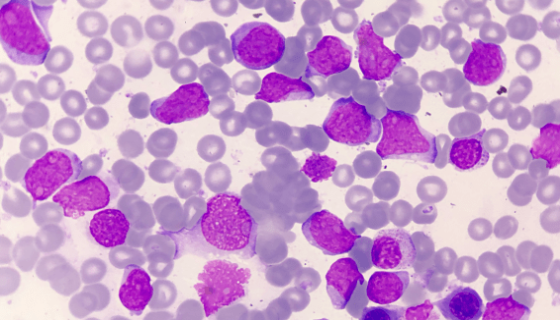
细胞淋巴瘤细胞的性质与用途及生产工艺！

细胞淋巴瘤细胞的性质与用途及生产工艺!
细胞淋巴瘤细胞收到后的处理方法与培养步骤及注意事项有哪些?

人嗜酸性粒细胞的复苏与传代及冻存操作说明!
嗜酸性粒细胞是白细胞的组成部分,与其他粒细胞一样来源于骨髓的...

ONS-76人脑髓母瘤细胞的培养方法与注意事项!
人脑髓母瘤细胞的处理方法与培养步骤及注意事项有哪些?

兔肝鳞癌肿瘤细胞收到后处理方法与培养步骤!
兔肝鳞癌肿瘤细胞收到后的处理方法与培养步骤及注意事项有哪些?

多变根毛霉的培养条件与注意事项及打管说明!
多变根毛霉是毛霉科的一种真菌。生物具体分类:真菌界-接合菌门...

短柄帚霉——电工电子产品试验菌
短柄帚霉,属于壳霉目,杯霉科,拉丁名为Scopulariop...

牛主动脉内皮细胞的复苏与传代及冻存操作说明!
牛主动脉内皮细胞BAEC取自雄性牛,贴壁培养,仅用于科学研究...

紫芝的真菌学史与形态特征及主要价值与培育技术!
紫芝(灵芝科、灵芝属真菌)一般指紫灵芝。紫灵芝(学名:Gan...

McCoy小鼠成纤维细胞性质、用途与生产工艺!
小鼠成纤维细胞分离自小鼠皮肤组织的贴壁细胞,成纤维细胞是疏松...